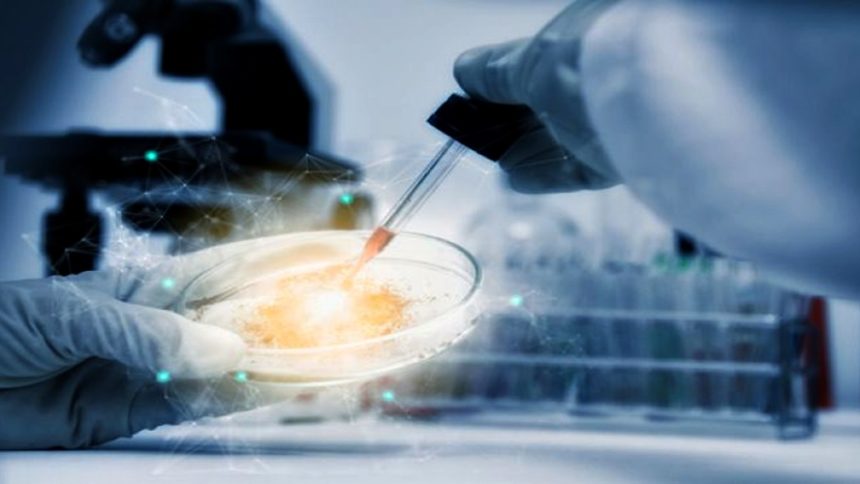

Της Άννας Παπαδομαρκάκη
Θα μπορούσαν βλαστοκύτταρα από το λίπος μας να υποκαταστήσουν τους βηματοδότες;
Το ενδεχόμενο αυτό επεξεργάζεται ο αναπληρωτής καθηγητής φαρμακολογίας Του Πανεπιστήμιου του Χιούστον, Bradley McConnell, με μελέτη του, με την οποία βοηθά στη δημιουργία μιας νέας εποχής για τους καρδιακούς βηματοδότες.
Χρησιμοποιεί βλαστοκύτταρα που βρίσκονται στο λίπος, τα μετατρέπει σε καρδιακά κύτταρα, τα επαναπρογραμματίζει και τα κάνει να δρουν ως κύτταρα ενός βιολογικού βηματοδότη.
Σύμφωνα με τη μελέτη που δημοσιεύθηκε στο Journal of Molecular and Cellular Cardiology, το νέο κύτταρο που προσομοιάζει με βηματοδότη θα είναι χρήσιμο ως εναλλακτική θεραπεία για αρρυθμίες, για την καρδιακή αποκατάσταση μετά από καρδιακή προσβολή, αλλά και για την αντιμετώπιση περιπτώσεων όπου η χρήση βηματοδοτών περιορίζεται.
“Χρησιμοποιούμε το καρδιακό προγονικό κύτταρο, το επαναπρογραμματίζουμε και το καθοδηγούμε να γίνει ένα αγώγιμο κύτταρο της καρδιάς για τη μεταφορά ηλεκτρικού ρεύματος”, δήλωσε ο καθηγητής McConnell.
Η χρήση λιπωδών μεσεγχυματικών βλαστοκυττάρων έχουν αποτελέσει και παλαιότερα αντικείμενο εργασιών. Στην συγκεκριμένη περίπτωση όμως τα καρδιακά προγονικά κύτταρα προγραμματίζονται, ώστε οι καρδιές να συνεχίζουν να χτυπούν σαν φλεβοκολπικός κόμβος, ο οποίος αποτελεί μέρος του συστήματος της καρδιακής ηλεκτροφυσιολογίας.
Ο φλεβοκολπικός κόμβος, είναι ο φυσικός βηματοδότης της καρδιάς, υπεύθυνος για τη δημιουργία της ηλεκτρικής ροής και των χτύπων της καρδιάς. Είναι μια μικρή δομή που αποτελείται από μια ομάδα κυττάρων στο δεξιό καρδιακό κόλπο, κοντά στην είσοδο της άνω κοίλης φλέβας. Η ανεπάρκειά του ή μπλοκάρισμα σε οποιοδήποτε σημείο του συστήματος καρδιακής ηλεκτροφυσιολογίας, έχει ως αποτέλεσμα τις αρρυθμίες.
Περισσότεροι από 600.000 ηλεκτρονικοί βηματοδότες εμφυτεύονται σε ασθενείς ετησίως για να βοηθήσουν στον έλεγχο των αρρυθμιών. Η μικρή μηχανική συσκευή τοποθετείται στο στήθος ή στην κοιλιά και χρησιμοποιεί ηλεκτρικούς παλμούς για να προτρέψει την καρδιά να κτυπήσει κανονικά. Εκτός από την τακτική εξέταση της συσκευής από γιατρό, με την πάροδο του χρόνου, ο ηλεκτρονικός βηματοδότης μπορεί να σταματήσει να λειτουργεί σωστά. Σε κάθε περίπτωση πρόκειται για ένα ξένο σώμα μέσα στον ανθρώπινο οργανισμό, με αποτέλεσμα, κατά τη χρήση βηματοδοτών να παρατηρείται ιδιαίτερα συχνά η ανάπτυξη λοιμώξεων, ενώ πολλές φορές υπάρχει αντένδειξη χρήσης, λόγω τραυματισμού.
“Οι μπαταρίες θα πεθάνουν, απλά κοιτάξτε το smartphone σας”, δήλωσε ο καθ. McConnell χαρακτηριστικά και πρόσθεσε: «Αυτός ο βιολογικός βηματοδότης είναι πιο ικανός να προσαρμόζεται στο σώμα και δεν θα χρειάζεται συντήρηση από τον γιατρό. Δεν είναι ξένο σώμα. Θα μπορούσε να αναπτυχθεί μαζί με το σώμα και να ανταποκρίνεται καλύτερα σε ότι λειτουργίες χρειάζεται το σώμα”.
Για τη μετατροπή των καρδιακών προγονικών κυττάρων, ο McConnell εγχύει στα κύτταρα ένα μοναδικό κοκτέιλ τριών μεταγραφικών παραγόντων και μια πρωτεΐνη μεμβράνης πλάσματος για τον επαναπρογραμματισμό τους στο δοκιμαστικό σωλήνα (in vitro).
Κατά τη διάρκεια της μελέτης, παρατηρήθηκε ότι το κοκτέιλ των τριών μεταγραφικών παραγόντων SHOX2, HCN2 και TBX5 (SHT5) και της πρωτεΐνης, επαναπρογραμματίζει τα κύτταρα και τα μετατρέπει σε κύτταρα που μοιάζουν με βηματοδότη.
Ο συνδυασμός αυτός, αναμένεται να διευκολύνει την ανάπτυξη κυτταρικών θεραπειών για διάφορες ασθένειες του συστήματος καρδιακής αγωγής.
Πηγή: Liberal.gr

Leave a comment